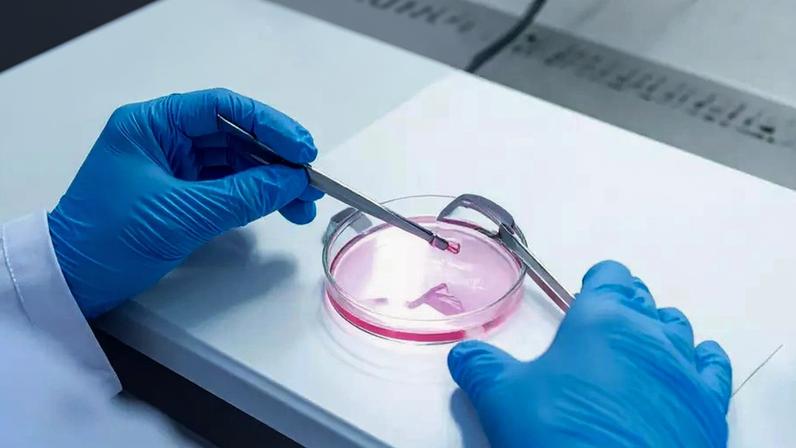
Congelar óvulos garante a gravidez? O Dr. Vinicius Bassega explica as vantagens e os mitos sobre a preservação da fertilidade e o impacto da idade biológica

- Congelar óvulos não garante gravidez no futuro; é uma forma de preservar a fertilidade para ter uma oportunidade, não uma certeza.
- A técnica preserva os óvulos com a idade biológica da coleta, mantendo o potencial de uso caso a mulher decida engravidar mais tarde.
- O sucesso depende do número de óvulos obtidos e da reserva ovariana no ato da coleta; não há garantia de gravidez.
- A decisão deve ser baseada em informação de qualidade, avaliação individual e expectativas realistas, com acompanhamento médico.
- O objetivo é oferecer uma opção e tranquilidade, sem prometer garantia de maternidade.
O congelamento de óvulos é apresentado como uma ferramenta de preservação da fertilidade, não como garantia de gravidez futura. O procedimento é utilizado por mulheres que desejam ganhar tempo para a vida profissional ou para buscar opções de parceria. O ginecologista Dr. Vinicius Bassega ressalta que ele aumenta as chances, desde que as expectativas sejam realistas.
Bassega explica que o congelamento faz sentido quando a mulher quer preservar a fertilidade para o futuro, levando em conta que a idade afeta tanto a quantidade quanto a qualidade dos óvulos. A prática mantém o material genético no estágio biológico da coleta, o que pode beneficiar situações em que a mulher decide engravidar mais tarde.
É essencial entender que o congelamento não funciona como seguro absoluto de maternidade. O sucesso depende do número de óvulos coletados e da reserva ovariana no ato da coleta. O médico alerta que a preservação oferece uma possibilidade, não uma certeza, e que o acompanhamento é fundamental para alinhar expectativas com a realidade clínica.
A decisão de realizar o procedimento deve se basear em informações de qualidade e avaliação individualizada. Para algumas mulheres, a estratégia pode trazer tranquilidade; para outras, pode não ser adequada. A vida reprodutiva demanda decisões tomadas com base no momento de vida de cada pessoa.
Vantagem da idade biológica
O benefício central do congelamento é manter a saúde dos óvulos no momento da coleta. Se a paciente extraiu os óvulos aos 30 anos, a gravidez futura pode ocorrer com o vigor da juventude do material armazenado. A idade biológica preservada é um ponto-chave na avaliação clínica.
A idade não é o único fator determinante. Variáveis uterinas e condições de saúde também influenciam o resultado final, ressaltando a necessidade de avaliação médica ampla antes de avançar com o procedimento.

Entre na conversa da comunidade